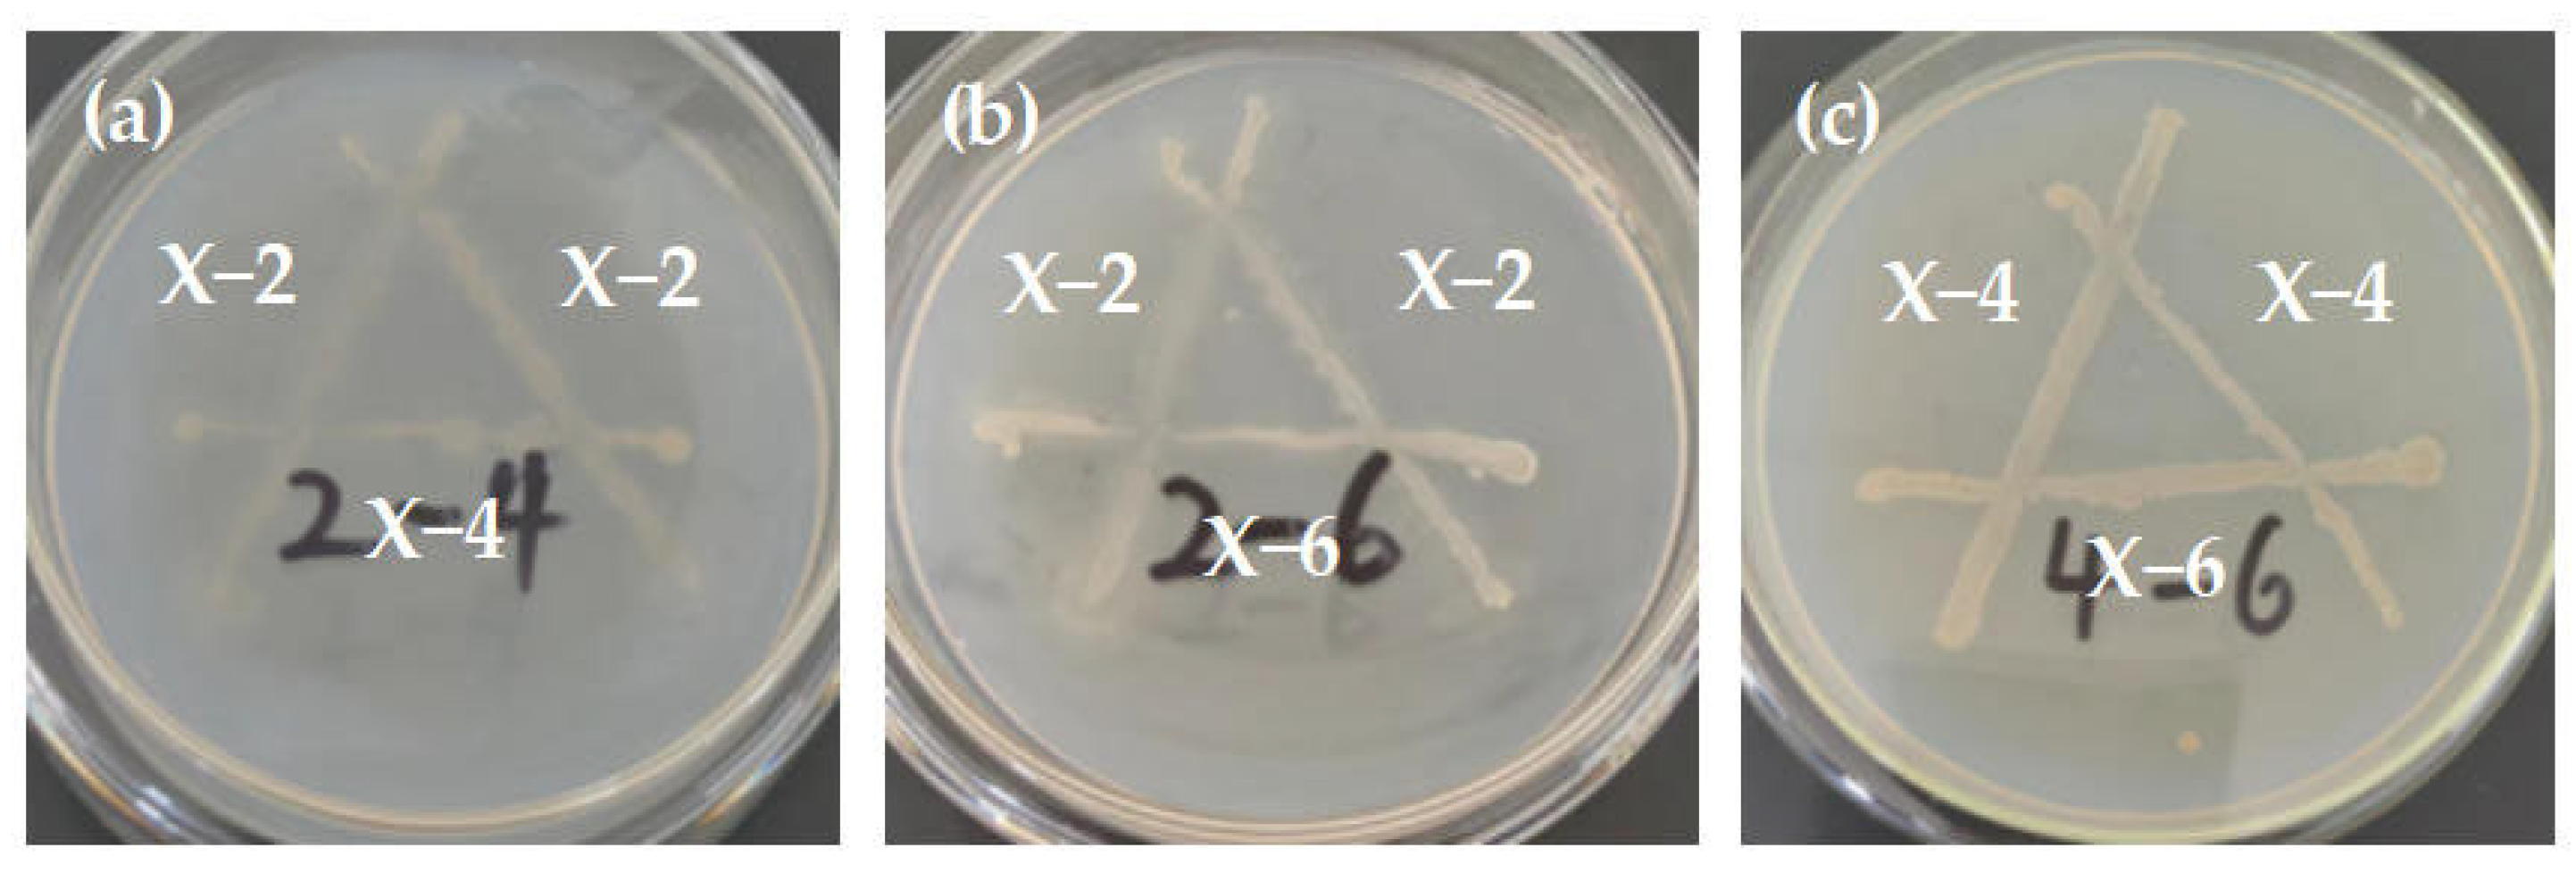
Agronomy 15 01947 g006 Agronomy 15 01947 g006

Preparation of a Bacterial Consortium for Straw Degradation and Optimization of Conditions for Its Return to the Field
Abstract
1. Introduction
2. Materials and Methods
2.1. Soil and Straw
2.2. Strains and Medium
2.3. Enrichment and Separation of Straw-Degrading Bacteria
2.4. Screening of Efficient Straw-Degrading Bacteria
2.4.1. Hydrolysis Transparent Circle Measurement Experiment
2.4.2. Filter Paper Strip Disintegration Experiment
2.5. Strain Identification
2.6. Construction of Composite Degradation Bacteria
2.6.1. Antagonistic Experiment
2.6.2. Preparation of Bacterial Consortium Suspension
2.7. Determination of Cellulase Activity
2.8. Straw Degradation in Liquid Medium of Bacterial Consortium
2.9. Straw Returning Degradation Experiment
2.10. Optimization Experiment of Single Factor Conditions for Straw Degradation
2.10.1. The Effect of Amount of Bacterial Suspension on Straw Degradation Rate
2.10.2. The Effect of Straw Dosage on Straw Degradation Rate
2.10.3. The Influence of Initial pH on Straw Degradation Rate
2.10.4. The Effect of Reaction Temperature on Straw Degradation Rate
2.11. Optimization of Response Surface Conditions
2.12. Data Analysis
3. Results and Discussion
3.1. Results and Analysis of Hydrolysis Transparent Circle Experiment
3.2. Results and Analysis of Filter Paper Strip Disintegration Experiment
3.3. Results of Strain Identification
3.4. Results and Analysis of Antagonistic Experiment
3.5. Results and Analysis of Cellulase Activity Determination
3.6. Results and Analysis of Straw Degradation in Liquid Medium
3.7. Results and Analysis of Simulated Straw Returning Degradation
3.8. Results and Analysis of Single Factor Condition Optimization Experiment
3.9. Results and Analysis of Response Surface Condition Optimization
−0.0459BC − 0.0015BD + 0.0268CD − 0.1364A2 − 0.583B2 − 7.623C2 − 0.1224D2
4. Conclusions
Author Contributions
Funding
Data Availability Statement
Conflicts of Interest
Appendix A
| Number | A (%) | B (g) | C | D (°C) | Sdr (%) |
|---|---|---|---|---|---|
| 1 | 10 | 6 | 7 | 30 | 42.7 |
| 2 | 30 | 6 | 7 | 30 | 61.46 |
| 3 | 10 | 14 | 7 | 30 | 36.86 |
| 4 | 30 | 14 | 7 | 30 | 51.67 |
| 5 | 20 | 10 | 5 | 20 | 21.77 |
| 6 | 20 | 10 | 9 | 20 | 30.53 |
| 7 | 20 | 10 | 5 | 40 | 25.23 |
| 8 | 20 | 10 | 9 | 40 | 36.13 |
| 9 | 10 | 10 | 7 | 20 | 33.2 |
| 10 | 30 | 10 | 7 | 20 | 53.32 |
| 11 | 10 | 10 | 7 | 40 | 38.61 |
| 12 | 30 | 10 | 7 | 40 | 58.11 |
| 13 | 20 | 6 | 5 | 30 | 32.23 |
| 14 | 20 | 14 | 5 | 30 | 24.01 |
| 15 | 20 | 6 | 9 | 30 | 40.46 |
| 16 | 20 | 14 | 9 | 30 | 30.77 |
| 17 | 10 | 10 | 5 | 30 | 17.54 |
| 18 | 30 | 10 | 5 | 30 | 27.31 |
| 19 | 10 | 10 | 9 | 30 | 22.53 |
| 20 | 30 | 10 | 9 | 30 | 40.6 |
| 21 | 20 | 6 | 7 | 20 | 52.5 |
| 22 | 20 | 14 | 7 | 20 | 41.83 |
| 23 | 20 | 6 | 7 | 40 | 57.42 |
| 24 | 20 | 14 | 7 | 40 | 46.51 |
| 25 | 20 | 10 | 7 | 30 | 73.22 |
| 26 | 20 | 10 | 7 | 30 | 72.1 |
| 27 | 20 | 10 | 7 | 30 | 70.4 |
| 28 | 20 | 10 | 7 | 30 | 69.44 |
| 29 | 20 | 10 | 7 | 30 | 71.44 |
| Source | Sum of Squares | Degree of Freedom | Mean Square | F-Value | p-Value | |
|---|---|---|---|---|---|---|
| Model | 8082.99 | 14 | 577.36 | 230.05 | <0.0001 | significant |
| A | 850.59 | 1 | 850.59 | 338.92 | <0.0001 | |
| B | 253.18 | 1 | 253.18 | 100.88 | <0.0001 | |
| C | 233.47 | 1 | 233.47 | 93.03 | <0.0001 | |
| D | 69.41 | 1 | 69.41 | 27.66 | 0.0001 | |
| AB | 3.90 | 1 | 3.90 | 1.55 | 0.2330 | |
| AC | 17.22 | 1 | 17.22 | 6.86 | 0.0202 | |
| AD | 0.0961 | 1 | 0.0961 | 0.0383 | 0.8477 | |
| BC | 0.5402 | 1 | 0.5402 | 0.2153 | 0.6498 | |
| BD | 0.0144 | 1 | 0.0144 | 0.0057 | 0.9407 | |
| CD | 1.14 | 1 | 1.14 | 0.4562 | 0.5104 | |
| A2 | 1207.18 | 1 | 1207.18 | 481.01 | <0.0001 | |
| B2 | 564.44 | 1 | 564.44 | 224.90 | <0.0001 | |
| C2 | 6030.92 | 1 | 6030.92 | 2403.06 | <0.0001 | |
| D2 | 971.13 | 1 | 971.13 | 386.95 | <0.0001 | |
| Residual | 35.14 | 14 | 2.51 | |||
| Lock of Fit | 26.52 | 10 | 2.65 | 1.23 | 0.4545 | not significant |
| Pure Error | 8.61 | 4 | 2.15 | |||
| Cor Total | 8118.12 | 28 | ||||
| R2 = 0.9957 | RAd j 2 = 0.9913 | RPre 2 = 0.9795 | ||||


References
- Bi, Y.Y.; Gao, C.Y.; Wang, Y.J.; Li, B.Y. Estimation of straw resources in China. Trans. Chin. Soc. Agric. Eng. 2009, 25, 211–217. [Google Scholar]
- Przybył, J.; Wojcieszak, D.; Garbowski, T. Effect of Corn Stover Ensiling on Methane Production and Carbon Dioxide Emissions. Energies 2024, 17, 6179. [Google Scholar] [CrossRef]
- Mika, L.T.; Cséfalvay, E.; Németh, Á. Catalytic conversion of carbohydrates to initial platform chemicals: Chemistry and sustainability. Chem. Rev. 2018, 118, 505–613. [Google Scholar] [CrossRef]
- Fan, Y.C.; Yuan, Y.Q.; Li, T.; Lin, W.; Tang, X.W.; Liang, G.M.; Li, N.N. Effects of autumn tillage with straw return on soil physical characteristics of corn fields in the eastern loess plateau. Front. Environ. Sci. 2024, 12, 1362616. [Google Scholar] [CrossRef]
- Zhang, C.N.; Lv, X.; Liang, X.M.; Liang, X.M.; Peng, P.; Feng, Y.J. Effects of continuous eeturn of Bt corn straw on soil nutrients, enzyme activities, and microbial communities. Agronomy 2024, 14, 2737. [Google Scholar] [CrossRef]
- Liu, R.Z.; Borjigin, Q.; Gao, J.L.; Yu, X.F.; Hu, S.P.; Li, R.P. Effects of different straw return methods on soil properties and yield potential of maize. Sci. Rep. 2024, 14, 28682. [Google Scholar] [CrossRef]
- Zhang, S.; Li, M.; Cui, X.; Pan, Y. Effect of different straw retention techniques on soil microbial community structure in wheat–maize rotation system. Front. Microbiol. 2023, 13, 1069458. [Google Scholar] [CrossRef]
- Yuan, Y.; Liu, H.; Liang, Y.; Yuan, J.; Zhang, C.; Zhang, J.; Cai, H.; Wang, L. Effects of maize straw return modes on soil organic carbon content and aggregate stability in a mollisol in Northeast China. Mosc. Univ. Soil Sci. Bull. 2024, 79, 693–702. [Google Scholar] [CrossRef]
- Su, Y.C.; Xiang, Y.X.; Wang, S.S. Lignin degradation by coprinus comatus in corn stalk. Ind. Crops Prod. 2023, 200, 116906. [Google Scholar] [CrossRef]
- Vishnu Vyasa, G.; Narasingappa, R.B.; Prakash, K.V.; Bhavani, P.; Gagandeep, K.R. Prospecting cellulolytic bacteria from white grubs (Holotrichia serrata (F.) and Leucopholis coneophora Burmeister) native to Karnataka region. BMC Microbiol. 2025, 25, 121. [Google Scholar] [CrossRef]
- Zhu, N.; Yang, J.S.; Ji, L.; Liu, J.W.; Yang, Y.; Yuan, H.L. Metagenomic and metaproteomic analyses of a corn stover-adapted microbial consortium EMSD5 reveal its taxonomic and enzymatic basis for degrading lignocellulose. Biotechnol. Biofuels 2016, 9, 243. [Google Scholar] [CrossRef] [PubMed]
- Arora, D.; Gupta, P.; Jaglan, S.; Roullier, C.; Grovel, O.; Bertrand, S. Expanding the chemical diversity through microorganisms co-culture: Current status and outlook. Biotechnol. Adv. 2020, 40, 107521. [Google Scholar] [CrossRef] [PubMed]
- Wang, J.H.; Li, L.L.; Xu, H.; Zhang, Y.H.; Liu, Y.L.; Zhang, F.Y.; Shen, G.N.; Yan, L.Y.; Wang, W.; Tang, H.Z.; et al. Construction of a fungal consortium for effective degradation of rice straw lignin and potential application in bio-pulping. Bioresour. Technol. 2022, 344, 126168. [Google Scholar] [CrossRef] [PubMed]
- Hu, Q.B.; Cai, J.L.; Wu, Q.; Li, F.M. Efficient degradation of corn straw at low temperature using a novel co-cultured consortium LHWA. J. Biosci. Bioeng. 2025, 139, 194–205. [Google Scholar] [CrossRef]
- Meng, Y.; Gu, W.R.; Ye, L.F.; Chen, D.S.; Li, J.; Wei, S. Degradation of cry1Ab protein within transgenic Bt maize tissue by composite microbial system of MC1. J. Northeast Agric. Univ. (Engl. Ed.) 2014, 21, 10–17. [Google Scholar] [CrossRef]
- Li, Y.X.; Kuramae, E.E.; Nasir, F.; Wang, E.; Zhang, Z.G.; Li, J.; Yao, Z.M.; Tian, L.; Sun, Y.; Luo, S.Y.; et al. Addition of cellulose degrading bacterial agents promoting keystone fungal-mediated cellulose degradation during aerobic composting: Construction the complex co-degradation system. Bioresour. Technol. 2023, 381, 129132. [Google Scholar] [CrossRef]
- Huang, Q.Y.; Lv, J.X.; He, Q.Y.; Wu, Q.; Liu, M.Q. Screening and Determination of Cellulose-Degrading Strains and Their Utilization in Degrading Straw. J. Fudan Univ. (Nat. Sci.) 2022, 61, 34–42. [Google Scholar] [CrossRef]
- Wang, Z.Y.; Ji, Y.Y.; Shu, J.H.; Chen, G.J.; Zhang, R.; Wang, X.L. Screening of high-effciency lignocellulosic degrading bacteria and study on the degradation effect of straw by complex microbial systems. China Feed 2024, 15, 19–26. [Google Scholar] [CrossRef]
- Chen, H.X.; Pan, D.W.; Quan, Y.L.; Sun, H.R.; Zhao, L.N.; Zhang, Y.H. Screening of straw-degrading strains and construction of complex microbial system. China Brew. 2024, 43, 70–76. [Google Scholar]
- Wang, Y.R.; Kang, Z.C.; Zhu, G.P.; Wang, Y.; Qi, G.Q.; Yu, H.W. Optimization of low temperature resistant corn stalk degrading bacterial community and its effect. Acta Agric. Zhejiangensis 2022, 34, 2720–2727. [Google Scholar]
- Zheng, S.; Liu, J.Y.; Sun, L.M.; Wu, J.G. The combined application of swine manure and straw strips to the field can promote the decomposition of corn straw in “broken skin yellow” of black soil. BMC Plant Biol. 2025, 25, 218. [Google Scholar] [CrossRef] [PubMed]
- Zhao, X.; Yu, X.; Gao, J.; Qu, J.; Borjigin, Q.; Meng, T.; Li, D. Improvement of Saline–Alkali Soil and Straw Degradation Efficiency in Cold and Arid Areas Using Klebsiella sp. and Pseudomonas sp. Agronomy 2024, 14, 2499. [Google Scholar] [CrossRef]
- Zhang, S.N.; Han, S.C.; Yu, X.F.; Gao, J.L.; Hu, S.P.; Borjigin, N.; Borjigin, Q.; Guo, J.G.; Bai, J.F.; Zhang, B.Z.; et al. Successful Formulation and Application of Low-Temperature Bacterial Agents for Corn Stover Degradation. Agronomy 2023, 13, 1032. [Google Scholar] [CrossRef]
- Huang, Y.Y.; Huang, Y.L.; Zhang, X.; Zhao, Q.; Zhang, S.M.; Zhang, Z.Y.; Peng, Z.P. Isolation, identification and degradation characteristics of maize straw of low-temperature cellulose-degrading strain Pseudogymnoascus sp. SDF-LT. Soil Fertil. Sci. China 2024, 4, 222–227. [Google Scholar]
- Chen, L.L. Isolation and Identification of Corn Straw Degradation Bacteria and Its Degradation Properties; Heilongjiang University of Science and Technology: Harbin, China, 2019. [Google Scholar]
- Wang, X.G.; Tian, L.; Wang, E.Z.; Zhong, C.; Tian, C.J. Construction of Microbial Consortium for Efficient Degradation of Corn Straw and Evaluation of Its Degradation Effect. Biotechnol. Bull. 2022, 38, 217–229. [Google Scholar] [CrossRef]
- Wang, H.R. Preparation of Multifunctional Compound Fungicide and Its Improvement Effect on Straw Return; Jilin Agricultural University: Changchun, China, 2023. [Google Scholar] [CrossRef]
- Ran, Y.Z.; Linghu, M.L.; Ma, S.J.; Zhang, Z.C.; Tian, B.; Liu, J.; Xie, J.; Liu, K.; Hao, J.; Li, J. Screening of a Straw Degradation Strain and Study on Its Degradation Effect. J. Guizhou Univ. (Nat. Sci.) 2024, 41, 118–124. [Google Scholar] [CrossRef]
- Wang, W.F.; Liu, Y.X.; Xie, X.J.; Yang, J.; Zhao, Z.Q.; Wang, M.; Zheng, H.B. Screening of efficient cellulose degrading bacteria in cow manure compost and optimization of enzyme production conditions. Microbiol. China 2023, 50, 4796–4811. [Google Scholar] [CrossRef]
- Guo, Q.; Liu, R.; Xu, G.; Cao, Y.; Hu, S.L.; Zhao, B. Screening of a rice straw degrading bacteria strain and its degradation effect. J. Northwest A F Univ. (Nat. Sci. Ed.) 2025, 53, 102–112. [Google Scholar] [CrossRef]
- Li, J.; Li, J.; Yang, R.P.; Yang, P.; Fu, H.B.; Yang, Y.C.; Liu, C.W. Construction of Microbial Consortium to Enhance Cellulose Degradation in Corn Straw during Composting. Agronomy 2024, 14, 2107. [Google Scholar] [CrossRef]
- Han, Q.Y.; Bai, H.J.; Song, Y.; Wang, Z.H.; Lu, J.; Jia, Y.T. Construction of Bacterial Consortium with Efficient Degradation of Corn Straw and Analysis of Degradation Effect. J. North Univ. China (Nat. Sci. Ed.) 2025, 46, 359–368. [Google Scholar]
- Liu, X. Construction and Effectiveness of a High Efficient Complex Microbial System for Corn Straw Degradation; Northeast Agricultural University: Harbin, China, 2019. [Google Scholar]
- Qing, G.E.; Zhang, B.Z.; Wang, L.J.; Zhao, W.S.; Yu, X.F.; Gao, J.L. Construction and Evaluation Synergistic Effect of Corn Straw Degradation Microbial Compound. J. Maize Sci. 2024, 32, 46–54. [Google Scholar] [CrossRef]
- Chen, H.X. Screening of Straw Degrading Bacteria and Application of Compound Microbial Agent; University of Science and Technology Liaoning: Anshan, China, 2023. [Google Scholar] [CrossRef]
- Shikata, A.; Sermsathanaswadi, J.; Thianheng, P.; Baramee, S.; Tachaapaikoon, C.; Waeonukul, R.; Pason, P.; Ratanakhano- kchai, K.; Kosugi, A. Characterization of an Anaerobic, Thermophilic, Alkaliphilic, High Lignocellulosic Biomass-Degrading Bacterial Community, ISHI-3, Isolated from Biocompost. Enzym. Microb. Technol. 2018, 118, 66–75. [Google Scholar] [CrossRef] [PubMed]
- Zhang, S.H.; Su, X.H.; Ji, J.Y.; Sun, C.C.; Cheng, W.J.; Wang, A.N.; Chen, H. Screening and Characterization of Low-Temperature Fiber Degradation Bacteria from Corn Stalks. J. Jilin Agric. Univ. 2025, 1–10. [Google Scholar] [CrossRef]
- Zhang, Y.Y.; Bai, G.W.; Yu, J.H.; Wang, F.; Liu, L.J.; Zhu, L.; Wuyun, D.L. Screening, identification, and enzyme production condition optimization of a cellulose-degrading bacterial strain. Microbiol. China 2025, 1–20. [Google Scholar] [CrossRef]
- Song, Y.; Bai, H.J.; Hu, J.J.; Zhao, Q.C.; Han, Q.Y.; Ye, Y.H. Isolation and screening of straw cellulose degrading bacteria, construction of composite strains and optimization of enzyme production conditions. China Brew. 2023, 42, 108–114. [Google Scholar]
- He, Z.G.; Ding, B.P.; Ali, Q.B.; Liu, H.Y.; Zhao, Y.; Wang, X.J.; Hao, Y.Z.; Dong, H.; Divvela, P.K.; Juan, Y.H. Screening and isolation of cold-adapted cellulose degrading bacterium: A candidate for straw degradation and De novo genome sequencing analysis. Front. Microbiol. 2023, 13, 1098723. [Google Scholar] [CrossRef]
- Wang, L.Y.; Sun, J.J.; Zhang, X.T.; Liu, J.S.; Zhang, S.L.; Zhang, Z. Screening of Straw Degradation Microbial Groups and Optimization of Conditions Degradation. J. Shandong Agric. Univ. 2024, 55, 475–486. [Google Scholar]
- Bao, F. Selection, Enzyme Production Condition Optimization, and Enzyme Gene Expression of Cellulose-Degrading Bacteria; Yangzhou University: Yangzhou, China, 2024. [Google Scholar] [CrossRef]
- Huang, H.; Wang, J.H.; Leng, S. Construction and application of soil-amending microbial inoculant for straw decomposition. Int. Microbiol. 2025, 1–18. [Google Scholar] [CrossRef]

| SOM (g/kg) | pH | CEC (cmol/kg) | Bulk Density (g/cm3) | AN (mg/kg) | AP (mg/kg) | AK (mg/kg) | Clay (%) | Silt (%) | Sand (%) |
|---|---|---|---|---|---|---|---|---|---|
| 7.3 | 7.28 | 11.35 | 1.21 | 60.74 | 38.91 | 160.37 | 15.07 | 48.41 | 36.52 |
| Number | Medium | Medium Composition |
|---|---|---|
| 1 | Enrichment medium | CMC-Na 5 g, NaCl 5 g, KH2PO4 0.5 g, MgSO4·7H2O 0.5 g, CaCO3 0.2 g, corn straw powders 5 g, distilled water 1000 mL |
| 2 | Inorganic salt medium | KH2PO4 1 g, NaCl 0.1 g, MgSO4·7H2O 0.3 g, NaNO3 2.5 g, FeCl3 0.01 g, CaCl2 0.1 g, distilled water 1000 mL, pH 7.2–7.4 |
| 3 | CMC-Na medium | CMC-Na 15 g, NH4NO3 1 g, MgSO4·7H2O 0.5 g, KH2PO4 1 g, yeast extract 1 g, distilled water 1000 mL |
| 4 | Congo red CMC-Na medium | CMC-Na 15 g, NH4NO3 1 g, MgSO4·7H2O 0.5 g, KH2PO4 1 g, yeast extract 1 g, Congo red 0.2 g, agar 20 g, distilled water 1000 mL |
| Number | Factors | Levels | ||
|---|---|---|---|---|
| −1 | 0 | 1 | ||
| A | Bacterial suspension amount (%) | 10 | 20 | 30 |
| B | Straw dosage (g) | 6 | 10 | 14 |
| C | pH | 5 | 7 | 9 |
| D | Reaction temperature (°C) | 20 | 30 | 40 |
| Strain | D/mm | d/mm | D/d |
|---|---|---|---|
| X−1 | 10.28 | 2.92 | 3.52 |
| X−2 | 11.95 | 2.70 | 4.43 |
| X−3 | 9.86 | 3.08 | 3.20 |
| X−4 | 10.48 | 2.87 | 3.65 |
| X−5 | 8.69 | 3.22 | 2.69 |
| X−6 | 10.82 | 2.78 | 3.89 |
| X−7 | 9.13 | 2.74 | 3.33 |
| X−8 | 5.61 | 2.88 | 1.95 |
| Strain | Cultivation Days | ||||
|---|---|---|---|---|---|
| 0 d | 3 d | 6 d | 9 d | 12 d | |
| X−1 | − | − | + | +++ | ++++ |
| X−2 | − | + | + | ++++ | ++++ |
| X−3 | − | − | − | + | + |
| X−4 | − | + | ++ | ++++ | +++++ |
| X−5 | − | − | + | ++ | +++ |
| X−6 | − | +++ | +++ | ++++ | ++++ |
| X−7 | − | ++ | ++ | +++ | ++++ |
| CK | − | − | − | − | − |
Disclaimer/Publisher’s Note: The statements, opinions and data contained in all publications are solely those of the individual author(s) and contributor(s) and not of MDPI and/or the editor(s). MDPI and/or the editor(s) disclaim responsibility for any injury to people or property resulting from any ideas, methods, instructions or products referred to in the content. |
© 2025 by the authors. Licensee MDPI, Basel, Switzerland. This article is an open access article distributed under the terms and conditions of the Creative Commons Attribution (CC BY) license (https://creativecommons.org/licenses/by/4.0/).
Share and Cite
Niu, C.; Sun, L.; Tang, R. Preparation of a Bacterial Consortium for Straw Degradation and Optimization of Conditions for Its Return to the Field. Agronomy 2025, 15, 1947. https://doi.org/10.3390/agronomy15081947
Niu C, Sun L, Tang R. Preparation of a Bacterial Consortium for Straw Degradation and Optimization of Conditions for Its Return to the Field. Agronomy. 2025; 15(8):1947. https://doi.org/10.3390/agronomy15081947
Chicago/Turabian StyleNiu, Chao, Lina Sun, and Rui Tang. 2025. "Preparation of a Bacterial Consortium for Straw Degradation and Optimization of Conditions for Its Return to the Field" Agronomy 15, no. 8: 1947. https://doi.org/10.3390/agronomy15081947
APA StyleNiu, C., Sun, L., & Tang, R. (2025). Preparation of a Bacterial Consortium for Straw Degradation and Optimization of Conditions for Its Return to the Field. Agronomy, 15(8), 1947. https://doi.org/10.3390/agronomy15081947

